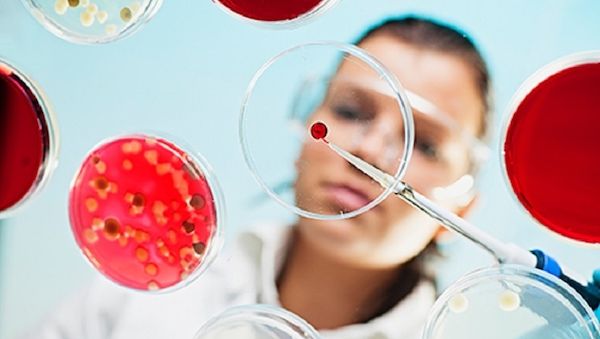
Bio-Recycling von Kunststoff: Mikroben machen aus Plastik neue Wertstoffe

In Baden-Württemberg erwartet die Menschen heute typisches Novemberwetter mit vielen Wolken und Niederschlägen. Es bleibt meist bedeckt, und es gibt wiederholt leichten Regen. Oberhalb von 400 bis 600 Metern fällt Schnee, der besonders in Nordstaulagen bis zu 10 Zentimeter Neuschnee bringen kann.
Die Temperaturen erreichen maximal 0 Grad im Bergland und bis zu 5 Grad im Rheingraben.
Bis in den Vormittag hinein besteht oberhalb von etwa 400 Metern gebietsweise Frost- und Glättegefahr. Gegen Abend klingen die Niederschläge allmählich von Nordwesten her ab. In der Nacht zum Donnerstag lockert die Bewölkung zwischendurch auf, allerdings bildet sich verbreitet Nebel mit Sichtweiten unter 150 Metern. Die Tiefstwerte liegen zwischen 0 Grad am Bodensee und minus 4 Grad auf der Schwäbischen Alb.
Für morgen zeigt sich das Wetter freundlicher: Nach örtlichem Nebel am Morgen wird es im Tagesverlauf zunehmend heiter bei Höchsttemperaturen von 0 Grad im Bergland bis 5 Grad im Rheintal. In der Nacht zum Freitag bleibt es meist gering bewölkt und trocken, mit erneuter Nebelbildung und Tiefstwerten bis minus 8 Grad in Oberschwaben.
Wetterbericht für Baden-Württemberg (26.11.2025)

Foto von dts
26. November 2025 - 06:15 Uhr
Von Peter Heidenreich